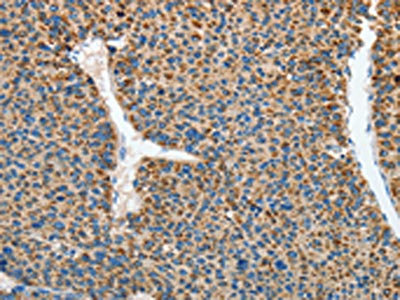

RCAN1 Antibody
-
中文名稱:RCAN1兔多克隆抗體
-
貨號:CSB-PA554520
-
規格:¥1100
-
圖片:
-
The image on the left is immunohistochemistry of paraffin-embedded Human liver cancer tissue using CSB-PA554520(RCAN1 Antibody) at dilution 1/45, on the right is treated with synthetic peptide. (Original magnification: ×200)
-
The image on the left is immunohistochemistry of paraffin-embedded Human brain tissue using CSB-PA554520(RCAN1 Antibody) at dilution 1/45, on the right is treated with synthetic peptide. (Original magnification: ×200)
-
Gel: 12%SDS-PAGE, Lysate: 40 μg, Lane 1-2: Mouse heart tissue, Mouse brain tissue, Primary antibody: CSB-PA554520(RCAN1 Antibody) at dilution 1/500, Secondary antibody: Goat anti rabbit IgG at 1/8000 dilution, Exposure time: 1 minute
-
-
其他:
產品詳情
-
Uniprot No.:
-
基因名:
-
別名:Adapt 78 antibody; Adapt78 antibody; Calcipressin 1 antibody; Calcipressin-1 antibody; Calcium and oxidant inducible mRNA antibody; CSP 1 antibody; CSP1 antibody; Down syndrome candidate region 1 antibody; Down syndrome critical region gene 1 antibody; Down syndrome critical region protein 1 antibody; DSC 1 antibody; DSC1 antibody; DSCR 1 antibody; DSCR1 antibody; MCIP 1 antibody; MCIP1 antibody; Modulatory calcineurin interacting protein 1 antibody; Myocyte enriched calcineurin interacting protein 1 antibody; Myocyte-enriched calcineurin-interacting protein 1 antibody; Near DSCR proline rich protein antibody; RCAN1 antibody; RCAN1_HUMAN antibody; RCN 1 antibody; RCN1 antibody; Regulator of calcineurin 1 antibody
-
宿主:Rabbit
-
反應種屬:Human,Mouse
-
免疫原:Synthetic peptide of Human RCAN1
-
免疫原種屬:Homo sapiens (Human)
-
標記方式:Non-conjugated
-
抗體亞型:IgG
-
純化方式:Antigen affinity purification
-
濃度:It differs from different batches. Please contact us to confirm it.
-
保存緩沖液:-20°C, pH7.4 PBS, 0.05% NaN3, 40% Glycerol
-
產品提供形式:Liquid
-
應用范圍:ELISA,WB,IHC
-
推薦稀釋比:
Application Recommended Dilution ELISA 1:2000-1:5000 WB 1:500-1:2000 IHC 1:50-1:200 -
Protocols:
-
儲存條件:Upon receipt, store at -20°C or -80°C. Avoid repeated freeze.
-
貨期:Basically, we can dispatch the products out in 1-3 working days after receiving your orders. Delivery time maybe differs from different purchasing way or location, please kindly consult your local distributors for specific delivery time.
-
用途:For Research Use Only. Not for use in diagnostic or therapeutic procedures.
相關產品
靶點詳情
-
功能:Inhibits calcineurin-dependent transcriptional responses by binding to the catalytic domain of calcineurin A. Could play a role during central nervous system development.
-
基因功能參考文獻:
- A novel mutation of g.482G>T in RCAN1 may be related to congenital heart diseases by causing overexpression of RCAN1. PMID: 28993896
- RCAN1.4 plays a novel role in regulating endothelial cell migration by establishing endothelial cell polarity in response to VEGF. PMID: 28271280
- Lycopene inhibits RCAN1-mediated apoptosis by reducing ROS levels and by inhibiting NF-kappaB activation, Nucling induction, and the increase in apoptotic indices in neuronal cells. PMID: 27928873
- Overexpression of RCAN1 markedly reduced glioma cells viability. PMID: 28061453
- RCAN1.4 prevents cell proliferation, migration, and invasion in vitro; overexpressed RCAN1.4 in HCC cells prevents growth, angiogenesis, and metastases of xenograft tumors by inhibiting calcineurin activity and nuclear translocation of NFAT1. PMID: 28583823
- elucidated a novel function of regulator of calcineurin 1 isoform 1 in mitochondria and provides a molecular basis for the regulator of calcineurin 1 isoform over-expression-induced mitochondrial dysfunctions and neuronal apoptosis PMID: 27861892
- our research revealed that RCAN1 was involved in the development of small cell lung cancer, and it might be a cancer-inhibiting gene for the formation of bone metastases in small cell lung cancer PMID: 28631570
- The results of the study indicate that RCAN1 is suppressed in endothelial cells of chronically inflamed periodontal tissues. During an acute infection, however, rcan1 seems to be upregulated in endothelial cells, indicating a modulating role in immune homeostasis of periodontal tissues. PMID: 27403036
- mRNA expression levels of DSCR1 and VEGF-C, and microvessel density are increased in cancerous tissues, compared with paracancerous tissue in hypopharyngeal cancer. PMID: 27922696
- The objective of this study was aimed to detect the association of Down syndrome critical region 1 (DSCR1) gene polymorphisms (rs149048873 and rs143081213) and congenital heart disease (CHD) susceptibility. PMID: 26569438
- Results support overexpression of RCAN1 and particularly the RCAN1.1S isoform during aging as a pathogenic mechanism in both Down syndrome-related and sporadic Alzheimer's disease PMID: 26497675
- RCAN1 can interact with IkappaBalpha and affect the phosphorylation of IkappaBalpha at tyrosine 42. PMID: 26492364
- The sequence variations in RCAN1 promoter are not major genetic factors involved in sporadic CHD, at least in the current research population. PMID: 25863471
- For DSCR1rs6517239, patients with an AA genotype had higher recurrence probability than patients carrying at least one allele G (37 +/- 4% SE vs. 15 +/- 6% SE) (HR: 0.51; 95% CI, 0.27-0.94; P = 0.027). PMID: 25379721
- E4BP4 and BIM regulation correlated with that of RCAN1-1. A putative GRE and four EBPREs were identified within 1500bp upstream from the transcription start site of RCAN1-1 PMID: 26102033
- The transcriptional regulation of RCAN1.1 and RCAN1.4 by two alternative promoters, is reported. PMID: 24751678
- Rcan1-1L may play a protective role in Ang II-treated cardiomyocytes through the induction of mitochondrial autophagy, and may be an alternative method of cardiac protection. PMID: 25978972
- Results show that Rcan1 isoform 1L (Rcan1-1L) overexpression specifically activates mitophagy and increases cell survival under hypoxic conditions. PMID: 25377251
- Data show that after IL-1beta treatment, the levels of reactive oxygen species and interleukin 8 (IL-8) mRNA of Down syndrome candidate region-1 (DSCR1)-transfected cells treated without BAPTA was significantly lower than those in pcDNA-transfected cells. PMID: 25218171
- Study showed that RCAN1 further contributes to Alzheimer's disease pathogenesis by increasing N-glycosylation and Abeta production PMID: 24720891
- These results suggest that USP22 positively regulates RCAN1 levels, which would consequently affect diverse RCAN1-linked cellular processes. PMID: 25546086
- results suggest the presence of a novel phosphorylation site in RCAN1 and that its phosphorylation influences calcineurin-dependent inflammatory target gene expression PMID: 25753203
- HDAC3, a new binding regulator of RCAN1, affects the protein stability and intracellular localization of RCAN1. PMID: 25144594
- This study demonstrates that increasing RCAN1 expression alters mitochondrial function and increases the susceptibility of neurons to oxidative stress in mammalian cells. PMID: 25009690
- RCAC1 cellular gene transcription was found to be regulated by NF-kappaB. PMID: 24359503
- Data indicate that neuron from Down syndrome candidate region 1 (DSCR1)-transgenic mice were more resistant than wild-type neurons to apoptotic cell death following 24 h of glucose deprivation. PMID: 23144708
- RCAN1 therefore facilitates T cell development and function, and when overexpressed, may contribute to immune dysfunction in Down syndrome. PMID: 23644448
- The resulte of this study demonistrated that RCAN1 isoform 4 effects may contribute to at least some of the observed phenotypes in individuals with Down syndrome and Alzheimer's. PMID: 23317802
- These findings suggest that up-regulation of RCAN1 expression followed by activation of the CREB pathway is required in GC-induced apoptosis. PMID: 23185487
- study found Kaposi's sarcoma herpesvirus K15 protein recruits PLCgamma1, and thereby activates Calcineurin/NFAT1-dependent RCAN1 expression which results in formation of angiogenic tubes PMID: 23028325
- a new regulatory mechanism of RCAN1 function PMID: 23118980
- results defined the regulatory mechanism underlying RCAN1 expression and the roles of RCAN1.1 in oxidative stress-induced neurodegeneration in AD and DS pathogenesis PMID: 23038757
- DSCR1 is a novel regulator of FMRP and Fragile X syndrome and Down syndrome may share disturbances in common pathways that regulate dendritic spine morphology and local protein synthesis PMID: 22863780
- DSCR1 gene has an important role in the occurrence and development process of laryngopharynx squamous cell carcinoma, and can influence the biological behavior of tumors. PMID: 22256743
- Co-immunoprecipitation/immunoblot analyses showed that STAT2 enhanced RCAN1 ubiquitination through the ubiquitin E3 ligase FBW7. PMID: 22426484
- This study suggested that upregulation of RCAN1 may be a valuable biomarker for AD risk. PMID: 21876249
- these data provide the first evidence that PKA acts as an important regulatory component in the control of RCAN1 function through phosphorylation. PMID: 22293192
- a direct link between Dyrk1A and RCAN1 in the Caln-NFAT signaling and Tau hyperphosphorylation pathways PMID: 21965663
- This article proposed that the mechanism by which stress can lead to neurodegeneration involves the inhibition of calcineurin and the induction of GSK-3beta by RCAN1 proteins. PMID: 21680892
- DSCR1-1L, regulated by a different promoter than DSCR1-4, activates NFAT and its proangiogenic activity is inhibited by cyclosporin. PMID: 17114339
- TEF3 mediates the expression of Down syndrome candidate region 1 isoform 1 (DSCR1-1L) in endothelial cells PMID: 18840614
- Regulator of calcineurin 1 (RCAN1) gene is a regulator on the activity of calcineurin and was reported to be overexpressed in Alzheimer's disease. PMID: 21838211
- RCAN1 regulated the calcineurin-NFAT signaling network in a dose-dependent manner. PMID: 21172821
- Regulator of calcineurin 1 (RCAN1) facilitates neuronal apoptosis through caspase-3 activation. PMID: 21216952
- Two distinct protein motifs in the C-terminal domain of RCAN1 are involved in binding to calcineurin and calcineurin inhibition PMID: 19332797
- The RCAN1 protein isoforms are phosphorylated proteins PMID: 12809556
- RCAN1 interacts with the catalytic subunit (calcineurin A) of the phosphatase calcineurin PMID: 10861295
- DSCR1 overexpression attenuates NFAT transcriptional activity in vascular smooth muscle cells. PMID: 19926569
- This study investigated the expression of IL-11 and role of prostaglandin F(2alpha)-F-prostanoid receptor (FP receptor) signaling in the modulation of IL-11 expression in endometrial adenocarcinoma cells. PMID: 20008143
- DSCR1-1S isoform positively modulates IL-1R-mediated signaling pathways by regulating Tollip/IRAK-1/TRAF6 complex formation. PMID: 19716405
顯示更多
收起更多
-
蛋白家族:RCAN family
-
組織特異性:Highly expressed heart, brain and skeletal muscle. Also expressed in all other tissues.
-
數據庫鏈接:
Most popular with customers
-
YWHAB Recombinant Monoclonal Antibody
Applications: ELISA, WB, IHC, IF, FC
Species Reactivity: Human, Mouse, Rat
-
-
-
-
-
-
-